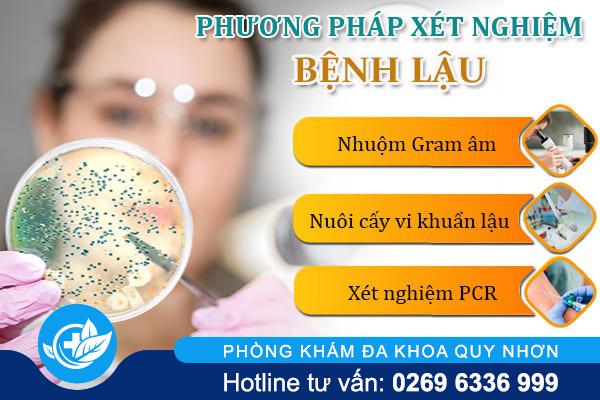

Hình ảnh thật, cân nhắc khi xem!
Tìm Hiểu Chi Phí Xét Nghiệm Bệnh Lậu Hiện Nay
Bệnh lậu là một trong những bệnh lây truyền qua đường tình dục phổ biến hiện nay, có tốc độ lây lan nhanh và tiềm ẩn nhiều biến chứng nguy hiểm. Tuy nhiên, nhiều người vẫn chần chừ trong việc thăm khám vì lo ngại về chi phí.
Vậy chi phí xét nghiệm bệnh lậu hiện nay bao nhiêu tiền? Có đắt không? Nên xét nghiệm ở đâu để vừa chính xác vừa tiết kiệm? Đồng thời, nếu mắc bệnh thì điều trị như thế nào hiệu quả?
Cần giải đáp? Liên hệ Hotline: 0269.6336.999 ngay hôm nay
Tổng Quan Về Bệnh Lậu
Bệnh lậu do vi khuẩn Neisseria gonorrhoeae gây ra, chủ yếu lây qua:
Quan hệ tình dục không an toàn (âm đạo, hậu môn, miệng)
Lây từ mẹ sang con khi sinh thường
Tiếp xúc với dịch tiết chứa vi khuẩn
Triệu chứng thường gặp:
✜ Tiểu buốt, tiểu rắt
✜ Chảy mủ màu vàng/xanh ở cơ quan sinh dục
✜ Đau khi quan hệ
✜ Ngứa, sưng viêm vùng kín
Ở một số trường hợp, bệnh có thể không có triệu chứng rõ ràng nhưng vẫn gây tổn thương âm thầm.
Liên hệ Hotline: 0269.6336.999 để được tư vấn và kiểm tra sớm tại Phòng khám đa khoa Quy Nhơn
Tầm Quan Trọng Của Việc Xét Nghiệm Sớm
Việc xét nghiệm giúp:
► Phát hiện bệnh ở giai đoạn sớm
► Xác định chính xác tác nhân gây bệnh
► Đưa ra phác đồ điều trị phù hợp
► Ngăn ngừa biến chứng nguy hiểm
Đặc biệt, những người có nguy cơ cao nên chủ động kiểm tra định kỳ.
Các phương pháp xét nghiệm bệnh lậu phổ biến:
1. Nhuộm soi (soi tươi)
– Ưu điểm: nhanh, chi phí thấp
– Nhược điểm: độ chính xác không cao bằng phương pháp hiện đại
2. Nuôi cấy vi khuẩn
– Ưu điểm: xác định chính xác vi khuẩn
– Nhược điểm: mất thời gian chờ kết quả
3. Xét nghiệm PCR (sinh học phân tử)
– Ưu điểm: độ chính xác cao, phát hiện sớm
– Nhược điểm: chi phí cao hơn
Hãy gọi ngay Hotline: 0269.6336.999 để được bác sĩ tại Phòng khám đa khoa Quy Nhơn tư vấn nhanh và kín đáo
Các Yếu Tố Ảnh Hưởng Đến Chi Phí Xét Nghiệm Bệnh Lậu
Chi phí xét nghiệm bệnh lậu phụ thuộc vào:
✤ Phương pháp lựa chọn
– Công nghệ càng hiện đại → chi phí càng cao
– Đổi lại, độ chính xác và phát hiện sớm tốt hơn
✤ Cơ sở y tế
– Bệnh viện công: chi phí thấp hơn nhưng thường đông
– Phòng khám tư: chi phí cao hơn nhưng nhanh, riêng tư

✤ Tình trạng sức khỏe
– Nếu cần xét nghiệm thêm các bệnh khác (HIV, giang mai…) → chi phí tăng
✤ Dịch vụ đi kèm
– Khám lâm sàng
– Tư vấn bác sĩ
– Tái khám
Khi Nào Cần Đi Xét Nghiệm?
Bạn nên đi xét nghiệm ngay khi:
Có dấu hiệu nghi ngờ bệnh
Quan hệ tình dục không an toàn
Có nhiều bạn tình
Bạn tình mắc bệnh xã hội
Việc xét nghiệm sớm giúp giảm chi phí điều trị và hạn chế biến chứng.
Cần giải đáp? Liên hệ Hotline: 0269.6336.999 ngay hôm nay
Cách Chữa Bệnh Lậu Hiện Nay
Sau khi có kết quả, bác sĩ sẽ chỉ định phương pháp điều trị phù hợp.
Điều trị bằng kháng sinh
– Có thể dùng thuốc uống hoặc tiêm
– Hiệu quả cao nếu phát hiện sớm
Điều trị chuyên sâu (trường hợp nặng)
– Áp dụng khi bệnh kéo dài hoặc tái lịa bằng phương pháp DHA hiện đại

Nguyên tắc điều trị
– Tuân thủ đúng phác đồ
– Không tự ý ngưng thuốc
– Điều trị cả bạn tình
– Kiêng quan hệ trong thời gian điều trị
Hãy gọi ngay Hotline: 0269.6336.999 để được bác sĩ tại Phòng khám đa khoa Quy Nhơn tư vấn nhanh và kín đáo
Phòng khám đa khoa Quy Nhơn – Địa Chỉ Xét Nghiệm Uy Tín
Nếu bạn đang tìm kiếm địa chỉ xét nghiệm và điều trị bệnh lậu an toàn, Phòng khám đa khoa Quy Nhơn là lựa chọn đáng tin cậy.
Tại Phòng khám đa khoa Quy Nhơn, bạn sẽ được:
Xét nghiệm nhanh – kết quả chính xác cao
Ứng dụng công nghệ hiện đại (PCR, nuôi cấy…)
Tư vấn riêng tư, bảo mật thông tin
Chi phí minh bạch, hợp lý
Đội ngũ bác sĩ chuyên khoa giàu kinh nghiệm
Ngoài ra, Phòng khám đa khoa Quy Nhơn còn hỗ trợ theo dõi và điều trị toàn diện, giúp người bệnh an tâm trong suốt quá trình.

Cách Tiết Kiệm Chi Phí Xét Nghiệm Và Điều Trị
Để tối ưu chi phí, bạn nên:
Đi khám ngay khi có dấu hiệu
Chọn cơ sở uy tín để tránh xét nghiệm lại
Tuân thủ điều trị để tránh tái phát
Khám sức khỏe định kỳ
Chi phí xét nghiệm bệnh lậu hiện nay không quá cao và có nhiều mức phù hợp với từng nhu cầu. Điều quan trọng là chủ động kiểm tra sớm để phát hiện và điều trị kịp thời.
Nếu bạn đang có dấu hiệu nghi ngờ hoặc cần kiểm tra, hãy lựa chọn cơ sở uy tín như Phòng khám đa khoa Quy Nhơn để được hỗ trợ nhanh chóng, chính xác và an toàn.